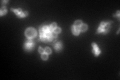
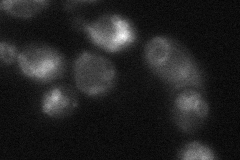

View description
Vacuolar membrane zinc transporter, transports zinc from the cytosol into the vacuole for storage; also has a role in resistance to zinc shock resulting from a sudden influx of zinc into the cytoplasm
Localization:
Intensity:
Fold change:
Significance:
-
C’ GFP library in SD
vacuole membrane117.28 -
N' NOP1pr-GFP in SD

vacuole membrane205.891 -
N' TEF2pr-mCherry in SD

vacuole membrane279.842 -
N' NATIVEpr-GFP in SD

vacuole membrane85.85 -
N' TEF2pr-VC and Cyto-VN in SD
vacuole membrane41.8196 -
C’ GFP library in SD+DTT

vacuole membrane83.450.71No -
C’ GFP library in SD+H2O2

vacuole membrane75.790.64Yes -
C’ GFP library in Starvation Media

vacuole membrane127.281.08No -
C’ GFP library on the background of Pup2-DaMP

vacuole membrane -
C’ GFP library on the background of CCT mutant

vacuole membrane91.59860.780993No
